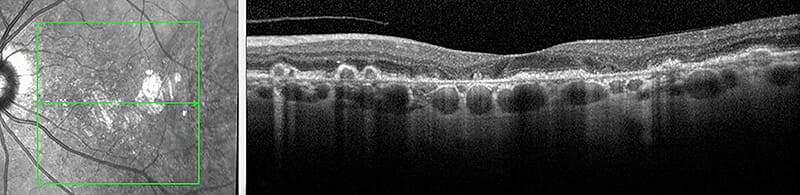
OCT scan of human retina cross-section.

Optical Coherence Tomography (OCT)
Optical Coherence Tomography, or OCT, is a non-invasive, fast-imaging, scanning technology that utilizes coherent light beams to document retinal structures or pathology. As it scans the macula, a detailed and magnified cross sectional image is produced which is used to document retinal structures and pathology. The retinal thickness is also measured which can aid in the diagnosis and monitoring of many retinal diseases. OCT usually takes only a few minutes.